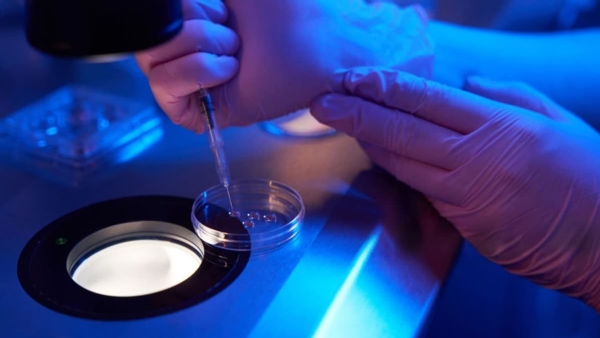
ILLEGAL EGG EXTRACTION

Enter your Email Address to subscribe to our newsletters
Lucknow, 08 ഫെബ്രുവരി (H.S.)
ഉത്തര്പ്രദേശില് പ്രായപൂര്ത്തിയാകാത്ത പെണ്കുട്ടിയുടെ അണ്ഡം നിയമവിരുദ്ധമായി ശേഖരിച്ച കേസില് അഞ്ച് പേരെ അറസ്റ്റ് ചെയ്തു. വ്യാജരേഖകള് മെനഞ്ഞ് പെണ്കുട്ടി വിവാഹിതയാണെന്ന് തെറ്റിദ്ധരിപ്പിച്ച കേസിലാണ് അറസ്റ്റ്. കേസില് വിശദമായ അന്വേഷണം നടത്തിവരികയാണെന്ന് ഫാഫമാവു പൊലീസ് അറിയിച്ചു.
വ്യാജ ആധാർ കാർഡും വ്യാജ സമ്മതപത്രവും ഉൾപ്പെടെ ഇവര് തയ്യാറാക്കിയതായി പൊലീസ് വ്യക്തമാക്കി. റിങ്കി ഹേല (32), പാലക് ഹേല (19), കൽപ്പന ഭാരതി (26), സീമ ഭാരതി (40), ഹിമാൻഷു ഭാരതി (19) എന്നിവരെയാണ് അറസ്റ്റ് ചെയ്തത്. പ്രയാഗ്രാജിലെ ഇന്ദിര ഐവിഎഫ് സെൻ്ററിലാണ് കേസിനാസ്പദമായ സംഭവം നടന്നത്. ഇരയുടെ അമ്മ നൽകിയ പരാതിയെ തുടർന്നാണ് പ്രതികളെ അറസ്റ്റ് രേഖപ്പെടുത്തി കസ്റ്റഡിലെടുത്തത്. വിശദമായ കേസ് അന്വേഷണത്തിനിടെയാണ് ആശുപത്രിയിലെ സംഘടിത റാക്കറ്റിനെ കുറിച്ച് പൊലീസ് വെളിപ്പെടുത്തുന്നത്.
പ്രതികരിച്ച് പൊലീസ്
പ്രാഥമിക ചോദ്യം ചെയ്യലിൽ നിരവധി ഞെട്ടിക്കുന്ന വിവരങ്ങൾ പുറത്തുവന്നതായി ഗംഗാനഗർ ഡിസിപി കുൽദീപ് സിങ് ഗുണവത് പറഞ്ഞു. ഇന്ദിര ഐവിഎഫ് സെൻ്ററിൻ്റെ രേഖകൾ പരിശോധിച്ചുകൊണ്ടിരിക്കുകയാണ്. മുൻകാല കേസുകളും സൂക്ഷ്മ പരിശോധനയിലാണ്.
പൊലീസ് എല്ലാ പ്രതികളെയും ചോദ്യം ചെയ്തുവരികയാണെന്നും സിങ് പറഞ്ഞു. മനുഷ്യക്കടത്ത്, വഞ്ചന, മെഡിക്കൽ ചട്ടങ്ങളുടെ ലംഘനം എന്നിവയുമായി ബന്ധപ്പെട്ട കൂടുതൽ കുറ്റങ്ങൾ ചുമത്തുമെന്ന് ഉദ്യോഗസ്ഥർ പറഞ്ഞു. കണ്ടെത്തലുകളുടെ അടിസ്ഥാനത്തിൽ കൂടുതൽ നടപടികൾ സ്വീകരിക്കുമെന്ന് പൊലീസ് വ്യക്തമാക്കി.
അതേസമയം മറ്റ് പെൺകുട്ടികളിലും സമാനമായ നിയമവിരുദ്ധ നടപടിക്രമങ്ങൾ നടത്തിയിരിക്കാമെന്ന് പൊലീസ് സംശയിക്കുന്നു. “പ്രായപൂർത്തിയാകാത്തവരെയും യുവതികളെയും പണം നൽകി നിയമവിരുദ്ധമായി അണ്ഡം വേര്തിരച്ചെടുക്കാന് പ്രേരിപ്പിക്കുന്ന റാക്കറ്റില് ഉള്പ്പെട്ടവരാണ് പ്രതികള്. ഈ ശൃംഖലയിൽ ഉൾപ്പെട്ട മറ്റ് ഏജൻ്റുമാരെയും പൊലീസ് തെരഞ്ഞു കൊണ്ടിരിക്കുന്നു” അദ്ദേഹം പറഞ്ഞു.
സംഭവം നടന്നത് ഇങ്ങനെ
ഇര ഒരു റെസ്റ്റോറൻ്റിൽ ജോലി ചെയ്തിരുന്നു. അവിടെ രണ്ട് യുവതികൾ മൊബൈൽ ഫോൺ വാങ്ങാൻ പണം വാഗ്ദാനം ചെയ്ത് സമീപിച്ചതായി പൊലീസ് പറഞ്ഞു. പിന്നീട് കൂപ്പർ റോഡിലെ താമസക്കാരായ സീമ ഭാരതിയെയും മകൻ ഹിമാൻഷുവിനെയും ഇരയ്ക്ക് പരിചയപ്പെടുത്തി നല്കി. അവർ ഷാഗഞ്ചിലെ ഒരു ഐവിഎഫ് സെൻ്ററില് ഏജൻ്റായി പ്രവര്ത്തിക്കുന്ന കൽപ്പന ഭാരതിയെ പരിചയപ്പെടുത്തി. ശേഷം, ഇവർ ഇരയുടെ വ്യാജ സമ്മത പത്രം തയ്യാറാക്കിയതായി പോലീസ് പറഞ്ഞു.
തുടര്ന്ന് റാക്കറ്റില് ഉള്പ്പെട്ട പ്രതികൾ സംയുക്തമായി വ്യാജ ആധാർ കാർഡും മറ്റ് രേഖകളും തയ്യാറാക്കിയതായി അന്വേഷണ ഉദ്യോഗസ്ഥർ വെളിപ്പെടുത്തി. ഈ രേഖകളുടെ അടിസ്ഥാനത്തിൽ ഇന്ദിര ഐവിഎഫ് സെൻ്ററിൽ നിന്ന് നിയമവിരുദ്ധമായി അണ്ഡങ്ങൾ കണ്ടെടുത്തു. നടപടിക്രമത്തിനായി പ്രായപൂർത്തിയാകാത്ത കുട്ടിക്ക് 10,000 രൂപ നൽകിയതായി ആരോപിക്കപ്പെടുന്നു.
---------------
Hindusthan Samachar / CHANDHU CHANDRASEKHAR